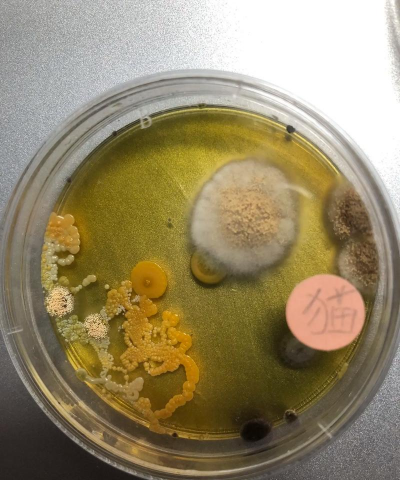
家庭养花用生根粉

富贵竹的生根水有哪些
富贵竹的生根水是指用于促进其根系生长的特殊水溶液,通常含有适量的营养成分,如腐殖土、营养液、糖分等,有助于加速富贵竹的根系发育。以下是几种常见的生根水配方和使用方法:
1. 腐殖土+糖+水混合液
- 成分:腐殖土(约50%)、白糖(约20%)、水(30%)。
- 作用:提供养分,促进根系生长。
- 使用方法:将腐殖土与白糖按比例混合,加水稀释后浇灌富贵竹。
2. 营养液+水混合液
- 成分:营养液(如含氮、磷、钾的复合液)+ 水。
- 作用:提供全面的养分,适合长期养护。
- 使用方法:按营养液说明书比例稀释后浇灌。
3. 稀释的淘米水
- 成分:淘米水(稀释后)。
- 作用:富含有机质,有助于改善土壤结构,促进根系生长。
- 使用方法:将淘米水稀释后浇灌,比例约为1:5(水:淘米水)。
4. 专用生根水
- 成分:含有生长素、氨基酸、腐殖酸等成分的专用生根液。
- 作用:促进根系快速生长,提高成活率。
- 使用方法:按照产品说明稀释后浇灌。
使用注意事项:
- 浓度控制:避免浓度过高,以免烧根。
- 浇灌频率:生根期一般每天一次,成活后可适当减少。
- 水质:建议使用清水或稀释后的淘米水,避免使用含氯水。
如果需要更具体的配方或使用方法,可以告诉我你目前的富贵竹生长情况,我可以为你提供更个性化的建议。
水稻怎样养花
水稻是一种重要的粮食作物,通常不用于“养花”,而是用于种植在农田中,为人类提供粮食。如果你是想了解如何“养花”,那么可能是指如何栽培花卉,而不是水稻。如果是这样,以下是一些关于花卉栽培的建议:1. 选择合适的花卉品种根据光照、温度、土壤条件
· 2025-11-14

佛手掌什么时间换土
佛手掌一般在春季进行换土,具体时间通常在3月至4月之间,此时气温适中,有利于植物生长和根系发育。换土时应选择疏松、排水良好的土壤,避免使用过于黏重或板结的土壤。此外,佛手掌对土壤的酸碱度有一定要求,建议使用pH值在6.0-7.0之间的土壤。
· 2025-11-14

驴粪养花行吗
驴粪可以用于养花,但需要根据具体情况判断其适用性。以下是相关分析:有机质丰富:驴粪富含有机质,有助于改善土壤结构。微量元素:含有一定量的氮、磷、钾等养分,但微量元素含量相对较低。微生物活性:驴粪中的微生物活性较高,有助于促进土壤微生物群落的
· 2025-11-14

蕨类植物有球茎的有哪些
蕨类植物中具有球茎的种类主要包括以下几种:鹿角蕨(Athyrium filix-femina):其球茎称为“球状体”,是其繁殖的重要结构,球状体成熟后可产生孢子囊,用于繁殖。鹿角蕨属(Athyrium):该属植物的球茎具有重要的繁殖功能,是
· 2025-11-14

卧室榻榻米养花
卧室榻榻米养花是一种将植物与生活空间结合的创意方式,但需要注意光照、通风和养护条件。以下是关于卧室榻榻米养花的一些实用建议和注意事项:耐阴植物:如绿萝、吊兰、仙人掌、常春藤等,适合光线较弱的环境。耐旱植物:如多肉、芦荟、仙人掌等,适合光照不
· 2025-11-14

葡萄什么时候换盆
葡萄换盆的时间通常在春季,具体时间为3月至4月之间,此时气温适中,有利于植株生长。换盆时应选择一个大小合适的新盆,盆底垫好排水层,如碎石、陶粒等,确保土壤排水良好。换盆步骤如下:修剪老根:去除老化、枯死或缠绕的根系,保持根系健康。更换土壤:
· 2025-11-14

树木花草枯萎代表什么
树木花草枯萎可能有多种原因,常见原因包括:病害:如根腐病、叶斑病等,可能导致植物枯萎。虫害:如蚜虫、红蜘蛛等,可能影响植物生长,导致叶片枯黄。缺水:植物缺乏水分会导致叶片枯黄、变脆。积水:过多的水分会导致根部腐烂,植物枯萎。缺肥:缺乏氮、磷
· 2025-11-14

无土养花细菌
无土养花是一种不使用土壤,而是通过其他介质如营养液、基质或水培系统来提供植物生长所需的养分和水分的种植方式。在无土养花的过程中,细菌在其中扮演着重要角色,尤其是在水培和基质培系统中。营养供给:某些细菌能够分解有机物质,将其转化为植物可吸收的
· 2025-11-14
可以插扦繁殖的花有哪些
在植物繁殖中,扦插是一种常见且有效的方法,适用于许多花卉和植物。以下是一些可以进行扦插繁殖的花:特点:玫瑰是典型的扦插繁殖植物,适合在春季进行。方法:选取健康、无病虫害的枝条,剪取15-20厘米长,保留2-3个芽,插入湿润的沙土中。特点:郁
· 2025-11-14

黄沙养花草
黄沙环境通常较为干燥、贫瘠,适合耐旱、抗逆性强的植物生长。在黄沙中养花草,需要注意以下几点:耐旱植物:如仙人掌、芦荟、多肉植物、沙地玫瑰、沙地郁金香等。耐盐碱植物:如枸杞、沙棘、碱蓬等。耐贫瘠植物:如地肤、蒲公英、紫云英等。沙土特性:黄沙颗
· 2025-11-14





